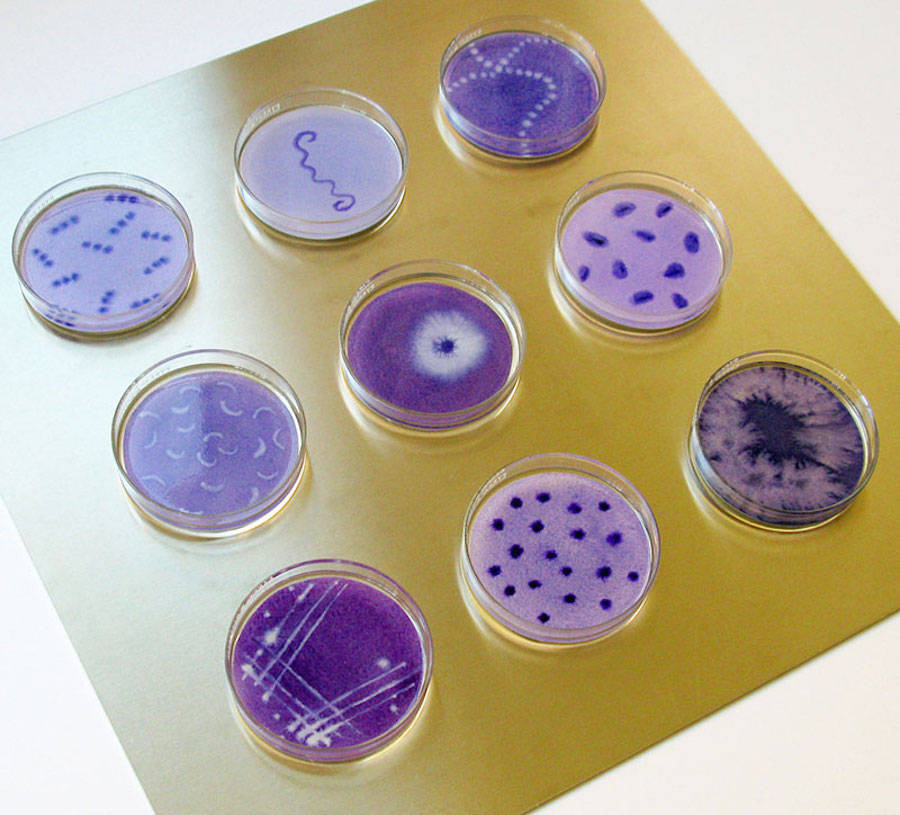
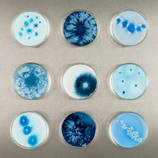

L’artiste Michele Banks s’inspire des expériences scientifiques sur des bactéries pour imaginer ses créations. Elle peint à l’aide d’aquarelle des bactéries fictives dans des coupelles destinées à l’observation au microscope. Le tout est ensuite fixé avec de la résine et monté sur un panneau en aluminum. Ce magnifique travail est à retrouver sur le shop Etsy de Michele Banks.